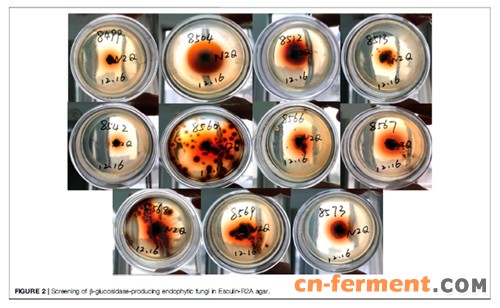

从钮子七(珠子参)中分离能产β-葡萄糖苷酶的内生真菌,再用产酶高的菌株转化人参皂苷提取物,高效液相(HPLC)分析转化的研究路径示意图。论文作者供图
产酶菌株筛选 论文作者供图
人参皂苷是传统名贵中药人参的主要活性成分,去糖基化的人参皂苷具有更强的药理活性,但其在自然界中含量极低;加之目前用于人参皂苷生物转化的商品化酶及微生物匮乏,稀有人参皂苷价格高昂,极大限制了其在大健康领域的应用。于是,探索将大量人参皂苷通过生物转化为高活性稀有人参皂苷的研究就成为药物学界等亟需解决的难点问题。
近日,陕西省微生物研究所薛文娇课题组在《药理学前沿》(Frontiers in pharmacology)在线发表论文,首次对产于秦岭的钮子七可培养内生真菌进行资源挖掘,获得种类丰富多样的β-葡萄糖苷酶产生菌及具有多样化的人参皂苷转化特性的研究成果。
钮子七属于五加科人参属植物,别称有珠子参、扣子七、竹鞭三七、疙瘩七、土三七、盘七、野三七等,可入药,具有止痛止血的功效,用于跌打损伤,外用治外伤出血。
为了获得可用于高活性稀有人参皂苷转化的新型β-葡萄糖苷酶及微生物资源,薛文娇课题组基于内生菌可能参与其宿主植物的次级代谢产物转化途径的理论假设,创新性开展了以皂苷为主要活性成分的药用植物钮子七内生真菌多样性及其转化人参皂苷活性研究。
“本研究共分离获得93株不同形态菌株,其中11株具有较强的β-葡萄糖苷酶活性,并展示出多样化的人参皂苷糖苷水解途径,具有用于稀有人参皂苷制备潜力。” 薛文娇介绍。
“另外,本研究首次发现Ilyonectria, Sarocladium和 Lecanicillium等3个属真菌具有人参皂苷转化能力,是新型β-葡萄糖苷酶的潜在来源。” 薛文娇进一步补充说明。
相关论文信息:https://www.frontiersin.org/articles/10.3389/fphar.2022.762862/full





















































